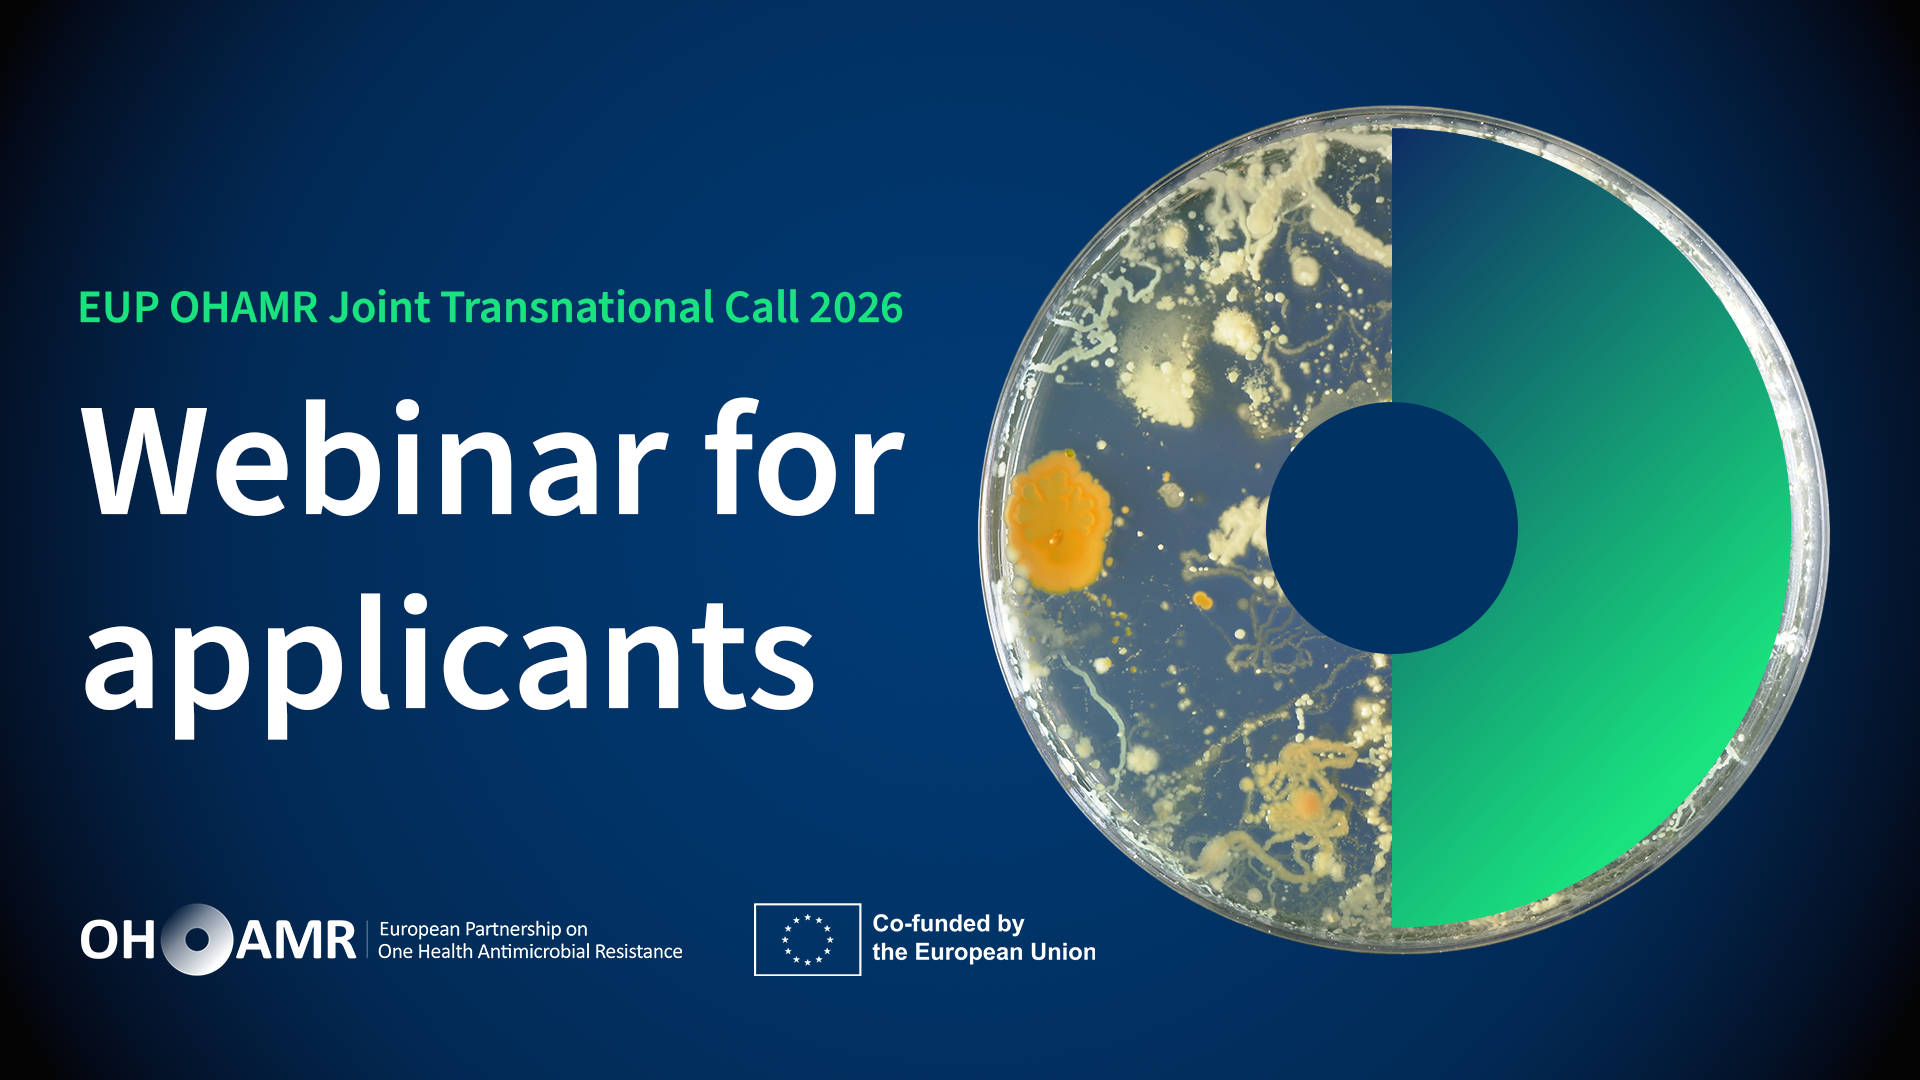
Tek Sağlık Antimikrobiyal Direnç Avrupa Ortaklığı (EUP OHAMR), 2026 ortak ilk uluslararası çağrısı “Tedaviler ve Tedavi Protokollerine Uyum” konulu web semineri 26 Kasım 2025 tarihinde düzenlenecektir.

Tek Sağlık – Antimikrobiyal Direnç Avrupa Ortaklığı (EUP OHAMR), “Tedaviler ve Tedavi Protokollerine Uyum” başlıklı 2026 ortak ilk uluslararası çağrısına yönelik web seminerini 26 Kasım 2025 tarihinde düzenleyecektir.
Tek Sağlık Antimikrobiyal Direnç Avrupa Ortaklığı (EUP OHAMR) tarafından, “Tedaviler ve Tedavi Protokollerine Uyum” başlıklı 2026 Ortak Uluslararası Çağrısı hakkında bir bilgilendirme web semineri düzenlenecektir. Etkinlikte, antimikrobiyal dirençle mücadeleye yönelik yeni tedavi yaklaşımları ele alınacak ve ortak çağrı sürecine ilişkin bilgiler aktarılacaktır.
Web semineri sırasında çağrıya katılan fonlayıcı kurumların temsilcileri; fon uygunluğu, araştırma iş birliklerinin nasıl bulunup kurulabileceği, başvuru süreçleri ve fonlama mekanizması gibi konularda katılımcıların sorularını yanıtlayacaktır. Kayıt formunu dolduran katılımcılara Zoom bağlantısı otomatik olarak iletilecektir.
Etkinlik kaydedilecek ve ardından EUP OHAMR web sitesinde erişime açılacaktır.
Etkinliğe kaydolmak için: Kayıt Linki
Çağrı hakkında ayrıntılı bilgi için: EUP OHAMR Ortak Uluslararası Çağrı 2026 (ohamr.eu).
EUP OHAMR hakkında yapılacak duyurulardan haberdar olmak isterseniz buradan elektronik bültene abone olabilirsiniz.
